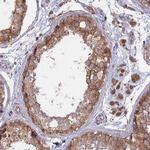
TMEM259 Antibody in Immunohistochemistry (IHC)

Search
Invitrogen
TMEM259 Polyclonal Antibody
{{$productOrderCtrl.translations['antibody.pdp.commerceCard.promotion.promotions']}}
{{$productOrderCtrl.translations['antibody.pdp.commerceCard.promotion.viewpromo']}}
{{$productOrderCtrl.translations['antibody.pdp.commerceCard.promotion.promocode']}}: {{promo.promoCode}} {{promo.promoTitle}} {{promo.promoDescription}}. {{$productOrderCtrl.translations['antibody.pdp.commerceCard.promotion.learnmore']}}

Please note: We are reviewing Western blot images included in the antibody testing data in our catalog, including those provided by third parties. Unless expressly labeled or annotated as “raw-unedited”, Western blot images included in the antibody testing data in our catalog may have been edited, optimized or otherwise adjusted for presentation.
产品信息
PA5-60072
种属反应
宿主/亚型
分类
类型
抗原
偶联物
形式
浓度
规格
纯化类型
保存液
内含物
保存条件
运输条件
RRID
产品详细信息
Immunogen sequence: IKFELDIEPK VFKPPSSTEA LNDSQEFPFP ETPTKVWPQD EYIVEYSLEY GFLRLSQATR QRLSIPVMVV TL
Highest antigen sequence identity to the following orthologs: Mouse - 92%, Rat - 90%.
靶标信息
Human membralin is unique and does not share significant sequence homology with other human genes, only membralins of other species. The membralin gene contains 11 exons which encode at least two spliced variants in human cancer. The long form of membralin (membralin-1) comprises all 11 exons, encoding a protein of 620-amino acids long and the short form of membralin (membralin-3) contains all exons except for exon 10, encoding a protein of 408 amino acids. Expression of different membralin isoforms depends on tissue type. The long form, membralin-1, is expressed in ovarian and colorectal carcinomas but not in breast or pancreatic carcinomas, which express only the short splice form, membralin-3. Recent studies suggest that membralin is a novel tumor-associated marker in ovarian serous carcinomas.
仅用于科研。不用于诊断过程。未经明确授权不得转售。




